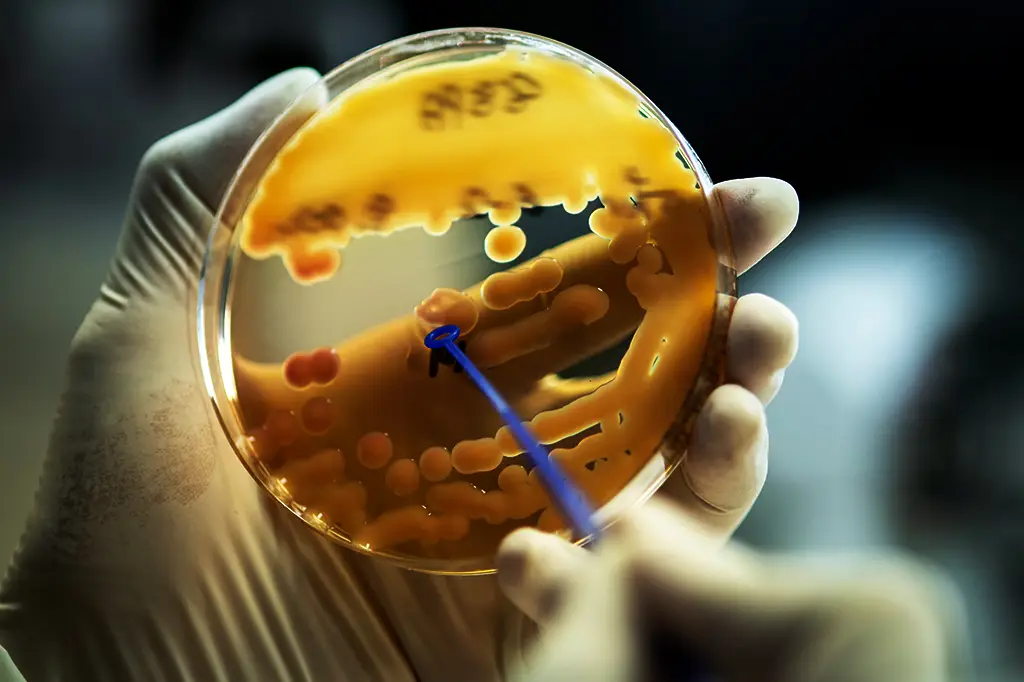
Cientistas descobrem antibiótico até 100 vezes mais potente que os atuais

Cientistas descobrem antibiótico até 100 vezes mais potente que os atuais
Pesquisadores localizam composto escondido em bactéria modelo que pode virar arma essencial contra superbactérias
Pesquisadores da University of Warwick (Reino Unido) e da Monash University (Austrália) anunciaram a descoberta de um composto antibiótico que se mostra até 100-vezes mais potente que alguns antibióticos existentes contra bactérias Gram-positivas resistentes.
A molécula, chamada pre‑methylenomycin C lactone, foi identificada como um intermediário biossintético no processo de produção do antibiótico conhecido methylenomycin A. O que chamou a atenção da equipe foi que esse “intermediário” vinha sendo ignorado até então — apesar de estar “à vista”, dentro de uma bactéria já bastante estudada: Streptomyces coelicolor.
Detalhes da descoberta:
- Em testes laboratoriais, o composto mostrou-se significativamente mais ativo contra bactérias como Staphylococcus aureus resistentes à meticilina (MRSA) e Enterococcus faecium resistente à vancomicina (VRE).
- Além disso, os pesquisadores não observaram, em experimentos iniciais, sinais de resistência bacteriana ao novo antibiótico — o que o coloca como uma esperança frente ao avanço global da resistência antimicrobiana.
- O estudo foi publicado na revista Journal of the American Chemical Society e marca um paradigma importante: em vez de buscar exclusivamente novos microrganismos desconhecidos, a pesquisa ressalta que intermediários de biossíntese já conhecidos podem esconder potências terapêuticas até então negligenciadas.
Implicações para a saúde pública:
A resistência antimicrobiana (RAM) é considerada pela World Health Organization uma das maiores ameaças globais à saúde pública. A lenta inovação em antibióticos e o uso indiscriminado dos existentes abrem caminho para infecções intratáveis. Nesse contexto, a descoberta ganha relevância enorme: se o composto for confirmado em testes clínicos, pode expandir o arsenal contra infecções graves e reduzir o impacto de superbactérias.
Cautelas e próximos passos:
Embora promissora, a descoberta ainda exige etapas consideráveis antes de se tornar medicamento aprovado:
- Avaliações pré-clínicas em modelos animais para verificar segurança, toxicidade e farmacocinética.
- Ensaios clínicos para humanos, bem como otimização da produção em escala.
- Monitoramento para possível surgimento futuro de resistência ao composto, bem como estudo de possíveis efeitos adversos.
Os autores reconhecem que “não estamos ainda com o remédio pronto para o mercado”, mas com uma nova rota de pesquisa que poderá gerar outros antibióticos potentes.
Conclusão:
A descoberta da pre-methylenomycin C lactone representa um lampejo de esperança na guerra contra a resistência bacteriana. Revela que, mesmo em microrganismos já estudados há décadas, podem estar escondidas moléculas com poder terapêutico extraordinário. Agora, resta transformar esse potencial em tratamento real — e acompanhar atentamente os benefícios para a saúde global.
